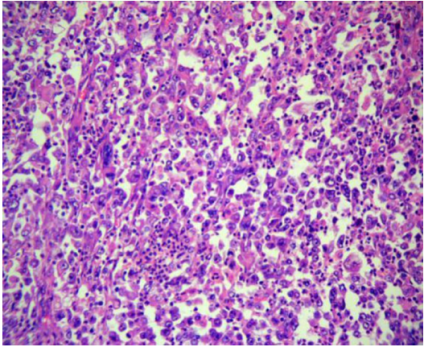

来源:医博士 | 2021-12-14 作者:李胜佳
妊娠期癌症的发病率约为0.07%~0.1%。近年来,随着生育年龄的推迟和青少年肿瘤发病率的增加,妊娠期恶性肿瘤的发病率呈上升趋势。妊娠期结直肠癌是一种罕见的疾病,其发病率约为0.002%,即13000例妊娠中有1例发生结直肠癌。本文报告一例妊娠期乙状结肠癌,结合病例报告,强调孕妇消化系统症状应引起重视。
病例介绍
36岁患者,怀孕38周零5天,孕期顺利。于2017年10月26日出现不明原因左上腹疼痛入院,持续4天。患者无恶心,呕吐及发烧,有便秘。血白细胞水平为12.99×109/L,C反应蛋白20mg/L,生化和凝血功能基本正常。肿瘤标志物增加,包括癌胚抗原(CEA)89.58 ng/mL(0–5 ng/mL)、癌抗原15-3(CA 15-3)148.60 U/mL(0–31 U/mL)、CA 125 104.50 U/mL(0–35 U/mL)、CA 19-9 1957.00 U/mL(0–35 U/mL)、CYFRA 21-1 12.6 ng/mL(0–3.3 ng/mL)、神经元特异性烯醇化酶(NSE)45.6 ng/mL(0–18 ng/mL),鳞状细胞癌(SCC)抗原4.04ng/mL(0-1.5ng/mL),甲胎蛋白(AFP)正常。
B超显示肝内多发低回声结节。最大的在左肝,大约3.4cm× 2.5cm,右肝约5.7cm× 5.2cm。两处边界清晰规则,内部可见血流迹象。MRI检查提示肝脏内有多个肿块,有转移的可能。在左下腹发现一个肿块,很有可能是恶性(图1)。

图1
经讨论,患者于2017年10月30日接受剖宫产,手术顺利。术后4天,患者出院,建议进行手术治疗。4天后,患者出现便血伴血凝块,血容量约为1000ml,并伴有头晕。
遂进行补液和抗休克治疗。胸部CT显示双肺结节影,提示可能有转移。腹部盆腔增强CT显示乙状结肠恶性肿瘤(结肠癌?),经三维重建病变后肠系膜上动脉供血,乙状结肠和直肠下部病变显示大量凝块。其次,在肠系膜下动脉根部、腹膜后间隙和门腔静脉间隙周围可见多个肿大淋巴结,并伴有坏死,提示可能有转移。此外,肝脏有多个转移瘤,大网膜种植性转移。
在介入室进行肠系膜上、下动脉的急诊动脉造影,并通过持续向肠系膜下动脉泵入垂体后叶素进行止血治疗(图2)。12小时后,患者病情稳定,转入外科病房。

图2
在积极改善后,于2017年11月9日进行了术前准备,随后进行了剖腹手术。在手术过程中,观察到腹部骨盆内有轻微血性腹水,约500ml,肝脏内有多个可触及的硬转移结节。在乙状结肠系膜一侧,发现一个直径约12cm的巨大肿瘤,肿瘤与肠壁相连,乙状结肠系膜几乎被肿瘤占据。肠系膜很难辨认,没有浸润到腹盆壁或附件的迹象。患者接受根治性乙状结肠切除术和结肠单腔瘘手术。术后病理证实乙状结肠恶性肿瘤,低分化(图3)。癌细胞穿透了浆液层。静脉内可见肿瘤血栓形成。手术部位两端均未发现癌残留。共有9/10肠系膜淋巴结转移。
图3
术后给予抗生素及营养支持治疗。患者间歇性发热38.3-38.7°C。手术后,血白细胞明显升高,术后25天血白细胞达到37.58×10^9/L。患者被转到肿瘤医院接受进一步治疗。术后32天(分娩后43天)因肿瘤多发转移及全身多器官衰竭死亡。
结论
妊娠期结直肠癌的临床表现并不特异,诊断和治疗是一个巨大的挑战。患者常被发现有晚期肿瘤,预后差。因此,临床医生应争取早期诊断,改善患者预后。对于有易感因素和家族史的高危人群,在计划怀孕前进行肿瘤筛查是必要的。
医博士编译自:ang H & Han X. Colorectal cancer in pregnancy: a case report and literature review. Journal of Gastrointestinal Oncology. 2021; 12(2):885-891.
声明: 所有注明“来源:医博士”的文字、图片和音视频资料,版权均属于医博士所有,转载须注明“来源:医博士”;所有转载文章系出于传递更多信息之目的,且明确注明来源和作者,不希望被转载的媒体或个人可与我们联系,我们将立即进行删除处理。